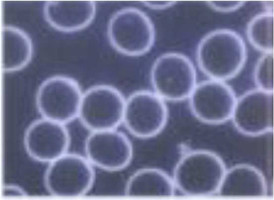

"Une seule question me préoccupa : Que peut-on faire pour agir contre l’épuisement de nos forces vitales à cause de l’excès de radiations pathogènes. Cette pensée fut aussi simple que géniale : l’information rendant malade doit être supprimée, c’est-à-dire neutralisée. Au moyen d’une interférence destructrice et de la connaissance de la polarité régénérative de droite."
Winfried M. Dochow, développeur de la technologie des harmonisateurs.
Notre opinion et conviction
Justement, à notre époque, on discute amplement si, et dans quelle mesure, des influences
environnementales négatives, qui peuvent être émises par la pollution électromagnétique, les zones géologiques perturbées et l’eau polluée, sont nuisibles et influencent négativement notre qualité de vie. On se dispute même pour savoir si la pollution électromagnétique ou les radiations terrestres existent vraiment et ce qui se cache dernière ces notions. Nous connaissons cela pareillement du passé sur des thèmes comme l’amiante, le formaldéhyde, l’acupuncture, le tabac. Vous vous en souvenez ?
Nous soutenons l’opinion que ces dangers, pas encore entièrement reconnus par la science officielle, provoquent bien des perturbations sanitaires, Et que, spécialement, l’influence énergétique des substances fines, comme la résonnance, la polarité et l’information, jouent ici un rôle important pour notre qualité de vie.
Comme la physique quantique, nous soutenons l’avis que l’information est un fondement essentiel de notre vie et que nous sommes entourés par un champ d’information. Différemment de ce que la science officielle actuelle soutient encore majoritairement, nous partons du point de vue que des ondes électromagnétiques artificielles portent des informations qui modifient les qualités d’information des organismes et qu’ainsi des informations pathogènes peuvent apparaître. Ceci agit négativement sur nous.
C’est pourquoi, de notre point de vue, il est indispensable de se protéger contre ces influences
omniprésentes, afin de pouvoir utiliser sans dommage les avantages de la technologie moderne et de rester en bonne santé psychiquement et physiquement.
Cette technologie propose pour cela des chemins et des solutions pour se protéger globalement dans l’espace de vie direct.
Les HARMONISATEURS neutralisent l’effet négatif et affaiblissant émis par la pollution
électromagnétique, réduisent le stress et procurent plus de qualité de vie.
Les HARMONISATEURS protègent des influences négatives des zones géo biologiques perturbées comme les veines d’eau, etc. Pour une récupération et une régénération profonde.
Les HARMONISATEURS optimisent le climat ambiant. La poussière fine dangereuse dans l’air respiré, qui pénètre en profondeur dans les poumons, est réduite. Moins de perturbation dans l’air. Respirer librement et en profondeur.
Les HARMONISATEURS sont développés et utilisables dans les domaines de vie les plus importants : à la maison, sur le lieu de travail, dans la voiture et en voyage. En téléphonant ou dans l’utilisation des technologies de communication modernes.
Comment des influences négatives peuvent-elles être modifiées positivement ?
En plus de deux décennies de travaux de recherches, la technologie innovante HARMONISEUR a été développée par Winfried M. Dochow, un technicien et développeur qui était déjà, à l’époque, bien en avance sur son temps. Une grave maladie le rendit conscient de l’importance profonde du thème. Ensuite, il travailla ensemble, entre autres, avec le renommé Institut Bolzmann et avec le centre Joanneum-Research : dans la recherche sur les champs électromagnétiques naturels et artificiels et
leur action sur l’être humain.
Dans un corps en bonne santé et vitalité chaque cellule exerce sa fonction et ne devrait pas être influencée. Si des cellules sont perturbées par des informations malades, elles émettent des faux signaux. La fonction cellulaire peut être perturbée et même totalement supprimée. Lorsque les systèmes de régulation biologiques sont en équilibre, la cellule est protégée.
Interférence destructrice. Un principe naturel physique.
Les HARMONISATEURS sont en mesure de neutraliser toutes les informations pathogènes, donc rendant malade, des champs électromagnétiques. Il y a derrière cela, ici dans le sens d’un modèle graphique de présentation, le principe naturel de l’interférence destructrice : si deux ondes de même longueur, même fréquence, même cadence, c’est-à-dire même phase et même amplitude, se rencontrent et si en plus ces ondes ondulent de manière opposée avec un décalage de phase à 180°, les deux ondes s'effacent mutuellement. Cela est utilisé par exemple dans les cockpits des avions, pour neutraliser le bruit des ondes sonores, afin qu’une compréhension soit possible.
Modèle graphique de présentation
Information nuisible – Oscillation de base

L’information nuisible est neutralisée, alors que l’oscillation technique de base reste inchangée.
Onde de base

" L’ADN reconnait les champs électromagnétiques et y réagit avec une réponse de stress biochimique. Les connaissances scientifiques nous disent que les valeurs limites de nos frontières de sécurité sont inaptes et que nous devons nous protéger contre les champs électromagnétiques des lignes à haute tension, des téléphones mobiles et identiques."
Prof. Dr. Martin Blank, électrobiologie, Université de Columbia.
Un avantage c’est bien. Sept avantages c’est mieux !
Les HARMONISATEURS neutralisent les influences négatives de l’environnement.
Ils neutralisent les informations négatives pour l’organisme des champs électromagnétiques, des zones géo biologiques perturbées et des polluants dans l’eau. Ils réduisent le nombre de particules des poussières fines dans l’air respiré.
Les HARMONISATEURS agissent naturellement.
Ils se basent sur les principes de la nature et non sur des procédés électriques, chimiques ou magnétiques, qui peuvent avoir des effets négatifs.
Les HARMONISATEURS agissent globalement.
Ils ont été développés pour un environnement harmonieux : à la maison, au poste de travail, en voyage, dans l’industrie et les lieux publics. La palette étendue de produits harmonisant couvre un vaste champ d’utilisations. Effet global pour une vie meilleure.
Les HARMONISATEURS sont basés sur les toutes dernières connaissances de la recherche.
Le fondement étant les connaissances innovantes de la physique bio et quantique. Les HARMONISATEURS restaurent un environnement naturel qui est libre des informations pathogènes rendant malade.
Les HARMONISATEURS sont confirmés dans la pratique.
De plus en plus de chercheurs s’occupent de la technologie d’harmonisation. Ils ont testé les HARMONISATEURS en série de recherches et confirmé leur effet positif sur les organismes.
Les HARMONISATEURS sont d’utilisation conviviale.
Ils s’installent facilement et s’intègrent sans intervention sur le système électrique ou sanitaire existant ou se fixent au mobile. Simple et efficace.
Le risque devient visible :
Avant de téléphoner avec un mobile : Les globules rouges s’écoulent librement et sont agiles. Ils peuvent effectuer sans problème leur fonction, transporter l’oxygène et les substances nutritives dans les cellules, évacuer des cellules les toxines et les déchets.

Image sanguine après 10 minutes de conversation avec un portable : le sang s’est agglutiné. La fluidité est réduite. Le transport de l’oxygène est réduit. Le sang présente une influence négative massive :

Image sanguine après 10 minutes de conversation. Téléphone équipé de l’HARMONISATEUR MOBILE : le sang s’écoule librement et sans restriction :
Produits associés
Harmoniseur téléphone
Pour mobiles et Smartphones ouvrables. L'harmoniseur est simplement posé dans l’appareil sur la batterie.
Effets positives chez vous :
Wi-Fi
Bluetooth
Radiations mobiles
GPSHabitat max. 100 m²
Cette collection d'harmoniseur est la solution pour les maisons mono-famille et les immeubles collectifs, appartements, immeubles de bureaux, commerciaux ou industriels, locaux commerciaux, hôpitaux, cliniques, maisons de retraite, hôtels et restaurants, bateaux, et immeubles de toutes sortes.
L'appareil doit être installé en permanence sur une prise qui n'est pas nécessaire pour une autre application. La diode lumineuse (très discrète) sous le sceau bleu indique le contact avec le réseau électrique en service.
Jusqu’à 100 m² de surface habitable/utile. 90 x 69 x 54 mm (L x l x h) | 350 g
Habitat max. 200 m²
Cette collection est la solution pour les maisons mono-famille et les immeubles collectifs, appartements, immeubles de bureaux, commerciaux ou industriels, locaux commerciaux, hôpitaux, cliniques, maisons de retraite, hôtels et restaurants, bateaux, et immeubles de toutes sortes.
L'appareil doit être installé en permanence sur une prise qui n'est pas nécessaire pour une autre application. La diode lumineuse (très discrète) sous le sceau bleu indique le contact avec le réseau électrique en service.
Jusqu’à 200 m² de surface habitable/utile. 110 x 69 x 54 mm (L x l x h) | 400 g
Habitat max. 350 m²
Cette collection est la solution pour les maisons mono-famille et les immeubles collectifs, appartements, immeubles de bureaux, commerciaux ou industriels, locaux commerciaux, hôpitaux, cliniques, maisons de retraite, hôtels et restaurants, bateaux, et immeubles de toutes sortes.
L'appareil doit être installé en permanence sur une prise qui n'est pas nécessaire pour une autre application. La diode lumineuse (très discrète) sous le sceau bleu indique le contact avec le réseau électrique en service.
Jusqu’à 350 m² de surface habitable/utile.130 x 69 x 54 mm (L x l x h) | 425 g
Harmoniseur bracelet
Domaine d’utilisation:
L’accompagnateur idéal et esthétique pour l’extérieur: en bus, train, avion, partout et en permanence.
Effets positives chez:
Pollution électromagnétique
Stress environnementale
3 tailles disponibles : Taille M - Diamètre 16,5 - 17,5 cm et Taille L - Diamètre 20 - 21 cm Taille XL - Diamètre 26 - 27 cm
(merci d'indiquer la taille dans les commentaires de votre commande)
Bracelet en latex.
Voitures et Breacks
Domaine d’utilisation:
Voiture tourisme et breaks Dimensions: 61 x 40 x 50 mm
Effets positives chez:
Electrosmog
Poussière fines
Wi-Fi
Bluetooth
GPSHarmoniseur minibus,...
Domaine d’utilisation:
Pour minibus, mobile homes (jusqu'à 6m), tracteur.
Dimensions: 76 x 40 x 50 mm
Effets positives chez:
Electrosmog
Poussière fines
Wi-Fi
Bluetooth
GPSElectrique et hybrides
Domaine d’utilisation:
Pour minibus, mobile homes, caravanes et véhicules hybrides
Dimensions: 76 x 40 x 50 mm
Effets positives chez:
Electrosmog
Poussière fines
Wi-Fi
Bluetooth
GPSHabitat max. 500 m²
Cet appareil est prévu pour une surface habitable jusqu'à 500 m².
L'appareil doit être installé en permanence sur une prise qui n'est pas nécessaire pour une autre application. La diode lumineuse (très discrète) sous le sceau bleu indique le contact avec le réseau électrique en service.
145 x 69 x 54 mm (L x l x H) | 450 g
